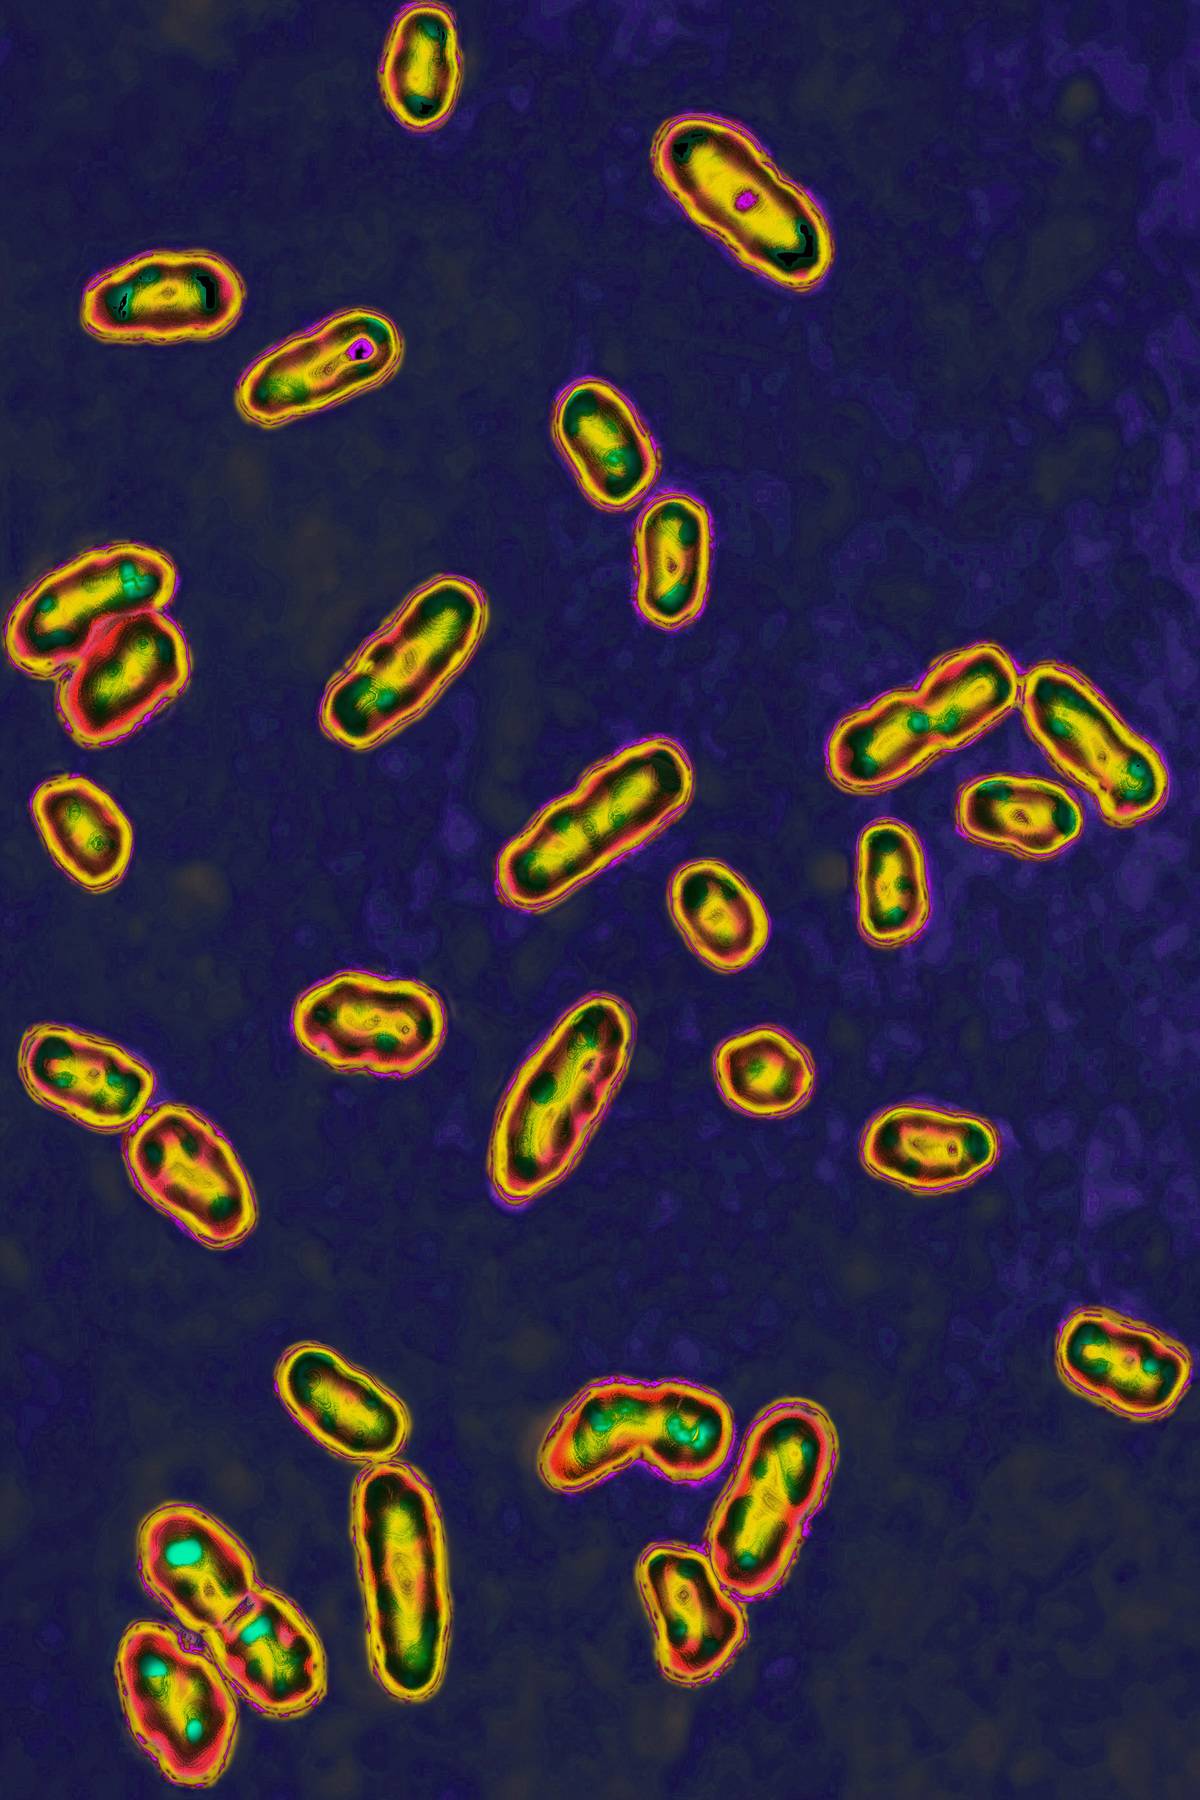
The bacteria Yersinia pestis is seen through a microscope.

20+ Unexpected health benefits of cooking and eating ginger
Ginger has been used for flavor and medicinal purposes for thousands of years. It’s not just for nausea; ginger can also delay diseases, guard the brain, and hinder the growth of bacteria. Here is what happens to your body if you eat ginger daily.
Ginger Has Been Medicinal For Thousands Of Years

Ginger was first used in southern China. From there, trading spread to India, western Asia, the Middle East, the Mediterranean, and eventually Europe.
Even thousands of years ago, ginger was known as a healing herb. Confucius apparently ate it with every meal. In 14th century England, a pound cost as much as a flock of sheep! But why was it so valuable?
The Ancients Knew Of Its Healing Properties

The ancients mainly used ginger to preserve meat, but they also knew of its healing properties. According to 2015 research, Iranian traditional medicine used it to improve digestive health and memory.
These medicinal benefits overlapped with spiritual. For instance, the Austronesian peoples used ginger to protect ships against spirits. But many of ginger’s healing associations ended up being true.
How Do Antioxidants Help?

According to Harvard Health Publishing, antioxidants are any compound that eliminates free radicals. Free radicals lack the proper amount of electrons, so they damage cell membranes and DNA by stealing their electrons.
Antioxidants supply these electrons, which prevents damage from free radicals. In 2004, research in Biofactors confirmed that ginger contains a high amount of antioxidants.
It Might Even Lower The Risk Of Chronic Diseases

Because free radicals and chronic inflammation contribute to a variety of diseases, ginger can counteract this. In 2016, a study in Advances in Experimental Medicine and Biology concluded that gingerol might prevent chronic diseases.
Studies have linked ginger to treating diabetes, coronary heart disease, fatty liver disease, and others. Researchers saw evidence of that in a pool of 4,628 participants.
Eat It To Relieve Nausea

As the ancients predicted, ginger is highly effective against nausea. Several studies have confirmed that nausea can soothe an upset stomach.
The British Journal of Anaesthesia reported that ginger can aid motion sickness, morning sickness, and chemotherapy-induced nausea. However, it cannot stop vomiting episodes. Even ginger tea can alleviate stomach upset.
Cook With Ginger For Chronic Indigestion

Chronic indigestion, which is consistent pain in the upper part of the stomach, usually results from delaying emptying of the stomach. Ginger can speed up stomach emptying, according to 2019 research in Food Science & Nutrition.
In 2011, study participants with functional dyspepsia (indigestion with no known cause) ate ginger before soup. They had less stomach discomfort afterward.
Ginger Inhibits The Growth Of Bacteria
Why was ginger used to preserve meat? According to 2015 research in PLoS ONE, ginger extract inhibits the growth of bacteria.
As an anti-bacterial, ginger can even suppress harmful bacteria such as E. coli, Bacillus subtilis, and Salmonella typhi. That does not mean that ginger can help you eat raw meat, but it can keep you healthy.
It Really Can Protect Memory And Fight Alzheimer’s

Remember the ancient Iranian remedy of using ginger for memory? There is some evidence for that. In 2012, an animal study suggested that ginger could delay the onset of Alzheimer’s.
According to research in Drug Design, Development, and Therapy, ginger alleviates inflammation in the brain. This inflammation can gradually degrade the brain over time.
In Fact, It Sharpens Your Mind Overall

Even if you do not have a family history of dementia, your brain can still benefit from ginger. In 2012, researchers tested the cognitive function of women who ate daily doses of ginger extract.
After two months, the participants had faster reaction times and better working memory. This means that ginger can enhance your brain.
If You Eat It Daily, Your Blood Pressure Might Improve

In 2017, a study in Nutrition examined people who ate ginger every day. Researchers found that ginger dilates blood vessels, which reduces hypertension.
Hypertension, better known as high blood pressure, can contribute to heart disease, metabolic syndrome, stroke, kidney disease, memory failure, and dementia. If you take care of your blood pressure, your risk of these conditions will be much lower.
Ginger Is Anti-Diabetes

People who have or are at risk of having diabetes can benefit from ginger. In 2015, researchers reported that ginger can drastically reduce blood sugar.
Another study in Planta Medica found that ginger transports sugar into muscle cells. Usually, insulin does this, but ginger compounds can do it without insulin. This makes ginger root especially healthy for diabetics.
However, People On Diabetes Medicine Should Be Wary

Beware: ginger does not interact well with certain diabetes medications. Beta-blockers, anticoagulants, and insulin medications might produce side effects with ginger, according to NDTV.
Some diabetics can eat a moderate amount of ginger (less than four grams) safely. It might even help some treatments. If you’re worried, consult a medical professional.
It Also Lowers Harmful Cholesterol

The body produces two types of cholesterol: healthy HDL cholesterol, and unhealthy LDL. Ginger lowers LDL cholesterol, according to a 2018 study in Clinical & Medical Biochemistry.
During this study, participants ate five grams of ginger paste daily and had over 17% less cholesterol after three months. Less LDL cholesterol means a lower risk of heart disease and stroke.
Ginger Might Aid Weight Loss

There is some evidence that ginger can speed up weight loss. In 2015, a study on 80 obese participants noted that they lost weight while eating ginger.
Not only that, but the participants had a lower BMI, blood insulin levels, and fat. Granted, the participants consumed a high dose of two grams every day. But even moderate ginger consumption might help.
If You Want To Use Fresh Ginger…

To use fresh ginger, you’ll want to remove the skin first. You don’t have to use a knife; the edge of a teaspoon is enough to peel off the skin. Chop off extra hard tips with a knife.
After you peel the ginger, chop it into fine pieces. Since ginger is fibrous, it works especially well in pastes and sauces.
Ginger Could Alleviate Arthritis Joint Pain

Ginger can alleviate joint pain, especially symptoms of osteoporosis. In 2001, research in Arthritis and Rheumatism found that patients had less knee pain after eating ginger consistently.
According to Versus Arthritis, ginger reduces the number of chemicals that cause inflammation. As joint inflammation grows, it becomes more painful. Granted, ginger is not a replacement for pain medication.
It Can Reduce Menstrual Pain

People who experience menstrual cramps might appreciate a ginger remedy. During a 2009 study, 150 women took either ginger or NSAIDs. Ginger reduced pain as effectively as ibuprofen.
Ginger contains an anti-inflammatory enzyme called zingibain that represses the chemical prostaglandins. This chemical is responsible for uterus walls tightening, which is the main cause of cramps.
Thank The Cause Of Its Smell, Gingerol

Ginger contains the bioactive compound gingerol. Not only does gingerol create the root’s unique smell, but it is also responsible for most medicinal properties.
According to a 2014 study in Natural Product Communications, gingerol can “exhibit a variety of biological activities including anticancer, anti-inflammation, and anti-oxidation.” These benefits might prevent chronic illnesses.
But Pregnant Women Might Get Side Effects From Ginger

Women can eat ginger during pregnancy, but they must be careful. According to gynecologist and fertility specialist Dr. Bandita Sinha, “ginger should not be consumed in excess amounts.”
Ginger can prompt bleeding, which might increase the risk of miscarriages. Women with a history of miscarriage or blood clotting should be especially careful.
Ginger-Eaters Are Less Likely To Get Cataracts

Ginger can also protect people from cataracts. During a 2010 animal study, a daily dose of ginger delayed the onset of cataracts in rats.
This is likely due to ginger’s effect on diabetes. High blood sugar can damage blood vessels around the eyes. Since ginger lowers blood sugar, eating it will lower the risk of cataracts.
Fresh Ginger Is Anti-Viral

Ginger is also anti-viral. In 2012, researchers tested ginger against respiratory viruses. They concluded that ginger hinder viruses from attaching to cells.
These results only came from fresh ginger, not dried. Even so, it explains why ginger-filled foods–such as chicken soup and ginger tea–are often recommended for people with a cold.
Because Of This, Ginger Increases Immunity

Because ginger is an anti-bacterial and anti-viral, it can strengthen your immune system. The ancients often used ginger to guard against disease, which science has since supported.
After examining 61 studies, researchers concluded that ginger “can prevent various cancers, angiogenesis, and metastasis.” In short, people are less likely to get sick when they eat ginger consistently.
The Many Ways To Eat Ginger

If you don’t like eating ginger root, don’t fret. Ginger comes in many shapes and forms, and you can enjoy it in a variety of dishes.
Candied ginger softens the bitterness so that people can eat it for nausea. Meanwhile, ginger powder can be added to sauces and cooking. Pickled ginger makes a tasty condiment, and ginger tea can soothe the stomach.
Plus, Ginger Is Anti-Aging

Along with delaying disease, ginger can slow down aging. In 2019, researchers examined over 100 studies on ginger. They concluded that ginger has anti-aging effects on several organs, including the heart, brain, and skin.
Another study in the journal Foods found that ginger prevents free radical damage in the skin. This could fade scars, smooth wrinkles, and brighten your skin.
It Can Also Improve Your Smile

Believe it or not, ginger can even boost oral health. Gingerol can fight off infections and inflammation in your gums.
According to dentist Derek J. Chang, ginger can remove plaque, ward off cavities, lower your risk of gingivitis, and even alleviate toothaches. You don’t have to brush your teeth with ginger, either; just eat or drink it.
Are Supplements Better Than Fresh Ginger?

Ginger is available in supplements, but do those work better than fresh ginger? Dr. Roberta Lee, the vice chair of the Department of Integrative Medicine in Beth Israel Medical Center, said supplements work better for some issues.
Recipes often do not provide enough ginger to help joint pain or boost immunity. However, grating fresh ginger might give you enough.
Beware Of Ginger’s Side Effects

According to the National Center for Complementary and Integrative Health, ginger has some side effects. Although it can aid digestion, too much can cause stomach pain, diarrhea, gas, and bloating. Some people also experience heartburn.
People with blood disorders, such as hemophilia, need to be careful with ginger. It encourages bleeding and can interact with blood-thinning medications.
As An Anti-Inflammatory, Ginger Might Prevent Diseases

Inflammation is the body’s natural response to illness and wounds. While inflammation can be good, researchers from Vanderbilt University stated that they can overkill cells. Too much inflammation can mess up hormones, insulin, and fat tissue.
Over time, chronic, low levels of inflammation can contribute to a long list of diseases. Ginger counteracts this through its anti-inflammatory properties.